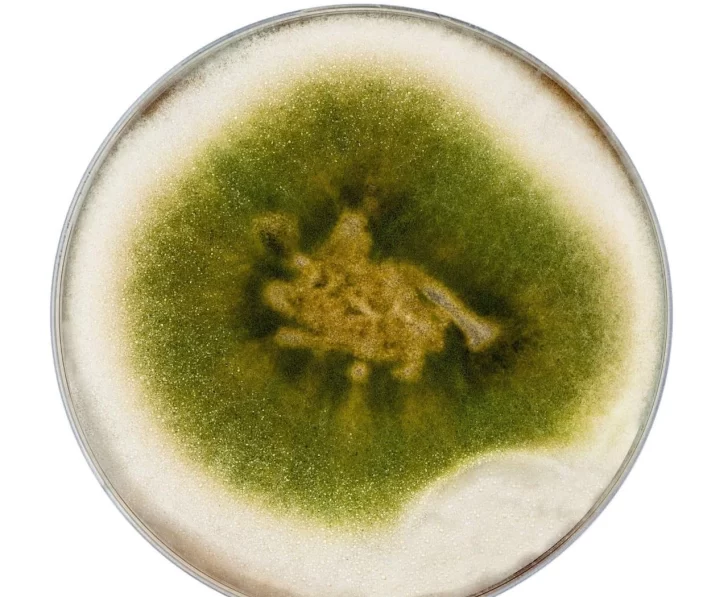

Los tiempos de la vitivinicultura cambian al ritmo del Agro 5.0 y su tendencia decidida a la reducción y reemplazo del uso de los agroquímicos por soluciones integrales que conjugan las nuevas biotecnologías con los secretos y la muñeca del manejo agronómico del viticultor con un sentido de triple cuidado: el ambiental, económico y social.
Este es el caso de la firma Biagro, que ofrece una solución biológica contra el oídio, peronóspora, botrytis y nematodos. Fundada en el año 1984, está ubicada en General Las Heras, provincia de Buenos Aires, consta de una vasta trayectoria en productos biológicos para cultivos extensivos, y ahora desea ampliarse a otros cultivos como la vid, presentando en San Juan y Cuyo Biagro TL.
Desde la empresa, el licenciado Marcelo Caliz destacó a Suplemento Verde de DIARIO DE CUYO que: "Lo que preocupa al mundo es el cambio climático; la degradación del suelo; la pérdida de biodiversidad debido a las explotaciones agropecuarias y el abuso de la utilización indiscriminada de químicos y cómo todo ello afecta a la alimentación de futuras generaciones".
En este sentido, "es que ponemos el foco en la microbiología, este es el camino que se viene. Tomando este desafío, presentamos Biaro TL Trichoderma afroharzianum, que es una excelente solución para los problemas que se presentan en el cultivo de la vid, los hongos del género Trichoderma son simbiontes endófitos, que colonizan las raíces y establecen una interacción con la planta-huésped", indicó Caliz.
Esta relación, "junto con su fácil adaptación a diversas condiciones climáticas y edáficas, y dado su velocidad de crecimiento los transforma en agentes de biocontrol".

TRICHODERMA
Se trata de "un hongo con actividad biofungicida con diferentes mecanismos de acción, produciendo antibióticos y compitiendo por nutrientes con los patógenos que se encuentran en el suelo".
Además de su acción como fungicida, "es considerado promotor de crecimiento debido a las fitohormonas que secreta, favoreciendo a la toma de nutrientes del suelo. También favorece al estado de la planta, frente a condiciones de estrés tales como podas, injertos, acodos o los ocasionados por enfermedades o plagas", agregó el empresario.
Es aconsejable "realizar su aplicación al comenzar el ciclo del cultivo para que el hongo penetre en las plantas y en el suelo y también es importante realizar dosificaciones foliares periódicas para asegurarse de que el hongo siga actuando. Conocemos las necesidades de este sector, y por ello ofrecemos un producto biológico, que además de todas las bondades antes descriptas no deja residuos".
MÁS DATOS:
Para más información pueden visitar la página web: www.biagro.com.ar